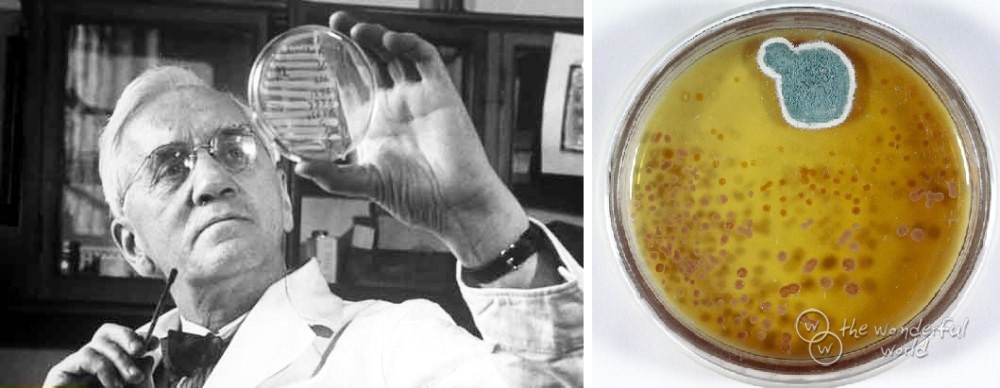

История открытия фото - найдено 30 изображений
Найдено изображений: 30

Смотрите также
- Автор проект фото
- Бесплатное фото девушек в хорошем качестве
- Водная станция владикавказ фото
- Доброе утро среды картинки прикольные необычные
- Как заменить габаритную лампочку солярис
- Как подключить разбитый телефон к компьютеру
- Как правильно подключить двигатель от стиральной
- Корейский суп рецепт с фото пошагово
- Красивый короткий маникюр квадратной формы
- Новые авто в россии фото цены

